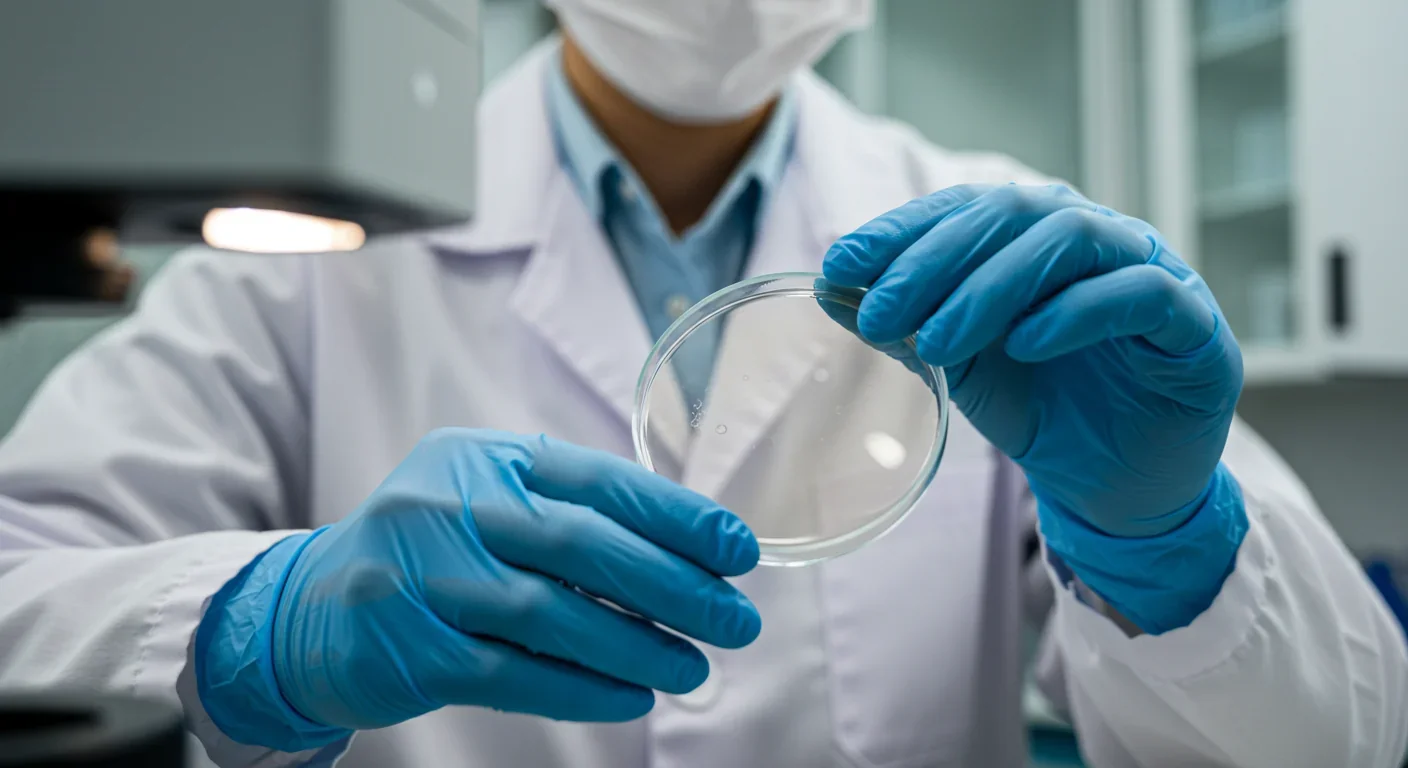
Microbiologist examining samples in laboratory setting during gut archaeome research

How Gut Bacterium Bt Unlocks Fiber's Hidden Nutrition

TL;DR: Ancient microorganisms called archaea inhabit your gut and perform unique metabolic functions that bacteria cannot, including methane production that enhances nutrient extraction. These primordial partners may influence longevity and offer new therapeutic targets.

Your body hosts ancient tenants that predate complex life itself. While scientists have spent decades studying the trillions of bacteria in your gut, they've largely overlooked an even more primordial group: archaea. These single-celled organisms emerged billions of years before bacteria evolved the ability to photosynthesize, and new research reveals they're performing metabolic functions in your intestines that bacteria simply cannot replicate. The discovery of this "archaeome" isn't just filling in a blank spot on the microbial map - it's fundamentally reshaping our understanding of what makes us human.
When scientists first began mapping the human microbiome, they focused almost exclusively on bacteria. It made sense at the time because bacteria outnumber human cells by a ratio of roughly 1.3 to 1. But archaea represent a completely separate domain of life, as distinct from bacteria as both are from plants and animals. They're not "ancient bacteria" - they're an entirely different form of life that happens to be ancient.
The key difference lies in their biochemistry. While bacteria have cell membranes made of ester lipids, archaea use ether lipids, which make them incredibly resilient to extreme conditions. Their genetic machinery is also unique, sharing more similarities with eukaryotes (organisms like us with complex cells) than with bacteria. This is why archaea were only recognized as a separate domain in the 1970s, even though they've been around for over three billion years.
Archaea are as different from bacteria as both are from humans - representing an entirely separate domain of life that's been living inside us all along.
In your gut right now, archaea make up between 0.4% and 1% of all microbial cells, depending on your age and health status. That might sound negligible, but it's roughly 400 billion to 1 trillion organisms performing chemistry that's unique in the animal kingdom.
The most important thing archaea do in your gut is produce methane. This might sound unimpressive - after all, cows are famous for their methane production - but the metabolic pathway involved is exclusive to archaea. No bacterium on Earth has evolved the enzymatic machinery to perform this reaction.
Here's why that matters: When bacteria ferment the food in your gut, they produce hydrogen gas as a waste product. Too much hydrogen slows down bacterial fermentation, reducing how much energy you can extract from your food. Archaea, particularly the species Methanobrevibacter smithii, consume that hydrogen and combine it with carbon dioxide to create methane. This process, called hydrogenotrophic methanogenesis, removes the hydrogen bottleneck and allows bacteria to work more efficiently.
Think of it as a metabolic partnership. Bacteria break down complex carbohydrates and proteins, producing short-chain fatty acids that your body uses for energy. But they also produce hydrogen that gums up the works. Archaea act as the cleanup crew, removing the hydrogen and allowing the whole digestive assembly line to run faster. Research has shown that the presence of M. smithii increases the amount of energy you can extract from food by allowing bacteria to shift their fermentation toward more oxidized end products.
"The removal of hydrogen by M. smithii allows an increase in the extraction of energy from nutrients by shifting bacterial fermentation to more oxidized end products."
- Research published in BMC Microbiology
This relationship is so important that scientists have a special term for it: syntrophy. Neither the bacteria nor the archaea could achieve these metabolic feats alone. They're locked in an obligate partnership that's been perfected over millions of years of co-evolution.
Recent studies have identified additional metabolic roles for archaea beyond methane production. They produce unique extracellular vesicles - tiny membrane-bound packages - that can carry proteins and metabolites to other cells. These vesicles may serve as communication channels between archaea, bacteria, and your own intestinal cells, though researchers are just beginning to understand their function.
For decades, archaea in the human gut were essentially invisible to scientists. Standard bacterial culturing techniques don't work well for archaea because they require very different growth conditions - often anaerobic environments with specific chemical compositions. Even when molecular techniques like 16S rRNA sequencing became standard for studying the microbiome, archaea were often missed because the primers designed to amplify bacterial DNA didn't bind well to archaeal sequences.

The breakthrough came with shotgun metagenomic sequencing, which sequences all the DNA in a sample without targeting specific genes. This unbiased approach revealed that archaea were present in virtually every human gut sample tested, though their abundance varied dramatically between individuals.
A landmark 2025 study analyzed the archaeome across three age groups: young adults, older adults, and centenarians. The findings were striking. The proportion of people with a "high methanogen phenotype" - meaning archaea make up a significant fraction of their gut microbiome - increased steadily with age: 25.2% in young adults, 41.86% in older adults, and 58.82% in centenarians.
Nearly 60% of centenarians have high levels of methane-producing archaea in their guts - more than twice the rate of young adults.
Even more intriguing, centenarians showed an archaeome composition that more closely resembled young adults than older adults. The dominant species in centenarians was Methanobrevibacter smithii, the same species that predominates in younger guts. In contrast, older adults (but not centenarians) showed increased levels of Candidatus Methanobrevibacter intestini, a newly discovered species that may have different metabolic properties.
This U-shaped pattern - where the very old resemble the young - suggests that maintaining a healthy archaeome might be one factor in extreme longevity. It's possible that centenarians have gut ecosystems that successfully resist age-related decline, or that their archaea provide some protective benefit that helps them live longer.
Unlike bacteria, which colonize your gut from multiple sources throughout life, archaea appear to be acquired primarily through a single route: breastfeeding. Methanobrevibacter smithii has been found in breast milk, and infants who are breastfed develop archaeal populations earlier and more consistently than formula-fed infants.

This vertical transmission - from mother to child - is different from the horizontal transmission common among bacteria, where you pick up new species from food, water, pets, and other environmental sources throughout your life. Once established, your archaeal population appears to be relatively stable, though its composition and abundance can shift based on diet, antibiotics, and health status.
Interestingly, not everyone harbors archaea. Studies suggest that 30-50% of people have essentially no detectable methane-producing archaea in their guts, while others have abundant populations. The factors determining who becomes colonized are still unclear, but early-life events - particularly infant feeding practices - appear to be critical.
So what happens if you're one of the people without archaea? The picture is complex and still emerging. Some research suggests that people without methane-producing archaea might be protected from certain digestive disorders, while other studies show potential benefits from having them.
On one hand, excessive archaeal populations are associated with Intestinal Methanogen Overgrowth (IMO), a condition linked to constipation, bloating, and slowed gut transit time. The theory is that too much methane production can affect the nerves controlling intestinal muscle contractions, leading to backup and discomfort. People with IMO often benefit from treatments that reduce archaeal populations.
On the other hand, archaea may provide important benefits. By improving the efficiency of bacterial fermentation, they help you extract more nutrients and energy from food. They also interact closely with butyrate-producing bacteria - species that generate short-chain fatty acids crucial for colon health and immune function. Network analysis shows that M. smithii acts as a hub species in centenarians, with strong positive correlations to beneficial bacterial groups like Oscillospiraceae and Christensenellaceae.
"In centenarians, Methanobrevibacter smithii has the highest betweenness and closeness centrality in the archaeal-bacterial co-occurrence network, indicating a key hub role."
- BMC Microbiology research team

More concerning, recent research has found associations between certain archaeal populations and disease. A 2025 preprint study found that M. smithii may be linked to colorectal cancer through its effects on the bacterial community. By altering which bacteria thrive in the gut, archaea may indirectly influence cancer risk. However, this research is preliminary and hasn't established causation - only correlation.
The discovery of the archaeome opens up entirely new therapeutic possibilities. Because archaeal cell membranes are chemically distinct from bacterial membranes, it's possible to target them selectively. Statins - the cholesterol-lowering drugs - actually inhibit archaeal growth while leaving bacteria unaffected. This happens because statins interfere with the synthesis of isoprene units, which archaea use to build their ether lipids but bacteria don't.
This suggests that we could potentially develop targeted treatments for IMO that reduce archaeal populations without disrupting beneficial bacteria. Current antibiotics tend to affect both bacteria and archaea, causing widespread disruption to the entire microbiome. An archaea-specific therapeutic would be far more precise.
Looking further ahead, researchers are exploring whether we could deliberately introduce specific archaeal strains as a form of microbial therapy. If the archaeome of centenarians truly does contribute to longevity, could we transplant those beneficial archaea into older adults to promote healthy aging? Could we give archaea to people with inefficient nutrient absorption to help them get more energy from their food?
Scientists are exploring archaea-specific therapies that could treat digestive disorders without disrupting beneficial bacteria - a precision approach impossible with current antibiotics.
These interventions would require us to solve significant technical challenges. Archaea are notoriously difficult to culture in the laboratory because they require highly specific anaerobic conditions. Growing M. smithii in vitro requires specialized equipment and expertise that few labs possess. But recent advances in anaerobic culturing techniques and the sequencing of complete archaeal genomes are making these organisms more tractable for research.
From an evolutionary standpoint, the human-archaeal partnership makes perfect sense. When our ancestors transitioned to more complex, fiber-rich diets, they needed microbial partners that could help break down otherwise indigestible plant materials. Bacteria evolved to ferment these compounds, but their efficiency was limited by hydrogen accumulation.
Archaea had already been producing methane for billions of years in ocean sediments, hydrothermal vents, and other extreme environments. At some point in our evolutionary history, these ancient methanogens found a new niche in the mammalian gut. The relationship was mutually beneficial: archaea got a steady supply of hydrogen and carbon dioxide in a warm, protected environment, while we got more efficient nutrient extraction.
This evolutionary partnership between humans and archaea is an example of co-evolution - where two species evolve in response to each other. The archaea in our guts are genomically distinct from their environmental relatives, suggesting they've adapted specifically to life in the human intestine. Meanwhile, our immune systems have learned to tolerate these foreign organisms, even though they carry molecular patterns that would normally trigger inflammatory responses.
The presence of archaea in our bodies is a reminder that we're not individual organisms but walking ecosystems. Every human carries roughly the same number of microbial cells as human cells, and among those microbes are representatives from all three domains of life: bacteria, archaea, and even some eukaryotic fungi and protozoans. We're composite beings, and our health depends on maintaining the right balance among all these partners.
Despite decades of microbiome research, scientists are still discovering new archaeal species in the human gut. In 2025, researchers identified a previously unknown methanogen using advanced genomic techniques. This new species was hiding in plain sight, misidentified in earlier studies because its genetic sequence was similar enough to known species that it was overlooked.
The discovery of Candidatus Methanobrevibacter intestini is particularly intriguing because it appears to have different metabolic capabilities than M. smithii. While both produce methane, they may interact differently with bacterial partners and respond differently to dietary changes. Understanding these differences could explain why some people respond differently to the same diets or develop different digestive symptoms.
More species almost certainly remain undiscovered. The human gut microbiome is estimated to contain hundreds to thousands of bacterial species, but we've only characterized a tiny fraction of the archaeal diversity. As sequencing technologies improve and more research groups turn their attention to the archaeome, we'll likely find that the archaeal component of our microbiome is far more diverse than current estimates suggest.
Each new species discovered raises new questions. Does it perform unique metabolic functions? Does it interact with different bacterial partners? Is it associated with particular health outcomes or dietary patterns? The archaeome is a frontier territory in microbiome science, and we're only beginning to map its landscape.
The recognition that ancient archaea are essential components of human biology represents more than just an academic curiosity. It changes how we think about ourselves and our place in the living world. The microbes in your gut aren't foreign invaders or passive hitchhikers - they're integral parts of your biology, performing functions your own cells can't accomplish.
This has practical implications for how we approach health and medicine. When you take antibiotics, you're not just killing disease-causing bacteria - you're disrupting an ancient ecosystem that includes archaea and their bacterial partners. When you change your diet, you're not just feeding yourself - you're feeding trillions of microbial partners whose metabolic activities affect your health.
The archaeome reminds us that life is fundamentally interconnected. The same methane-producing pathways that archaea perfected in primordial seas are still operating in your intestines today. The hydrogen that bacteria produce as waste is archaeal food. The methane that archaea excrete diffuses into your bloodstream, gets carried to your lungs, and leaves your body with every breath. You are quite literally exhaling the metabolic byproducts of organisms that predate complex life on Earth.
As research continues, we'll develop a more nuanced understanding of how to maintain a healthy archaeome. We'll learn which dietary patterns support beneficial archaeal populations and which disrupt them. We'll develop diagnostic tests that can identify archaeal imbalances before they cause symptoms. We may even develop probiotic supplements containing live archaea, though cultivating these finicky organisms at scale will require significant technological advances.
For now, the most important insight is simply recognizing that archaea exist and matter. They're not a biological footnote but a fundamental part of human biology that we've overlooked for far too long. Every person is a walking time capsule, carrying organisms whose ancestors were among the first life forms on Earth. Understanding how we coexist with these ancient partners may be key to understanding human health itself.

Saturn's moon Titan may harbour liquid water beneath its frozen crust, kept from freezing by ammonia acting as a natural antifreeze. New Cassini data suggests the interior could be slush with warm water pockets rather than a global ocean, and NASA's Dragonfly mission launching in 2028 aims to investigate whether this exotic environment could support life.

Bacteroides thetaiotaomicron uses 88 specialized gene clusters and over 260 enzymes to decode and digest dietary fibers humans can't break down, converting them into essential short-chain fatty acids. When fiber runs out, it eats your gut's protective mucus instead, with cascading health consequences.

Scientists are restoring Ice Age ecological dynamics through rewilding projects like Siberia's Pleistocene Park and de-extinction efforts by Colossal Biosciences. These initiatives aim to reintroduce megafauna or their proxies to repair broken ecosystems, protect Arctic permafrost, and slow climate change.

The cheerleader effect is a proven cognitive bias where people look more attractive in groups because the brain automatically averages faces, smoothing out individual flaws. Research shows the sweet spot is 3-5 people, it works for all genders, and it has real implications for dating apps and social media strategy.

The Hawaiian bobtail squid farms bioluminescent bacteria in a specialized light organ to erase its shadow in moonlit waters. This partnership, where bacteria reshape the squid's body and communicate through quorum sensing, is teaching scientists how host-microbe relationships work and inspiring new medical and biotech applications.

Millions are leaving social media platforms driven by privacy scandals, mental health concerns, and algorithmic manipulation. While 60% relapse within a week, those who stay away report dramatically improved wellbeing, and decentralized alternatives like Bluesky are surging.

Building a reliable quantum computer requires roughly 1,000 fragile physical qubits per logical qubit due to surface code error correction overhead. New code families like LDPC and neutral-atom platforms are racing to slash that ratio, with some teams claiming it could drop to as few as 5-to-1.